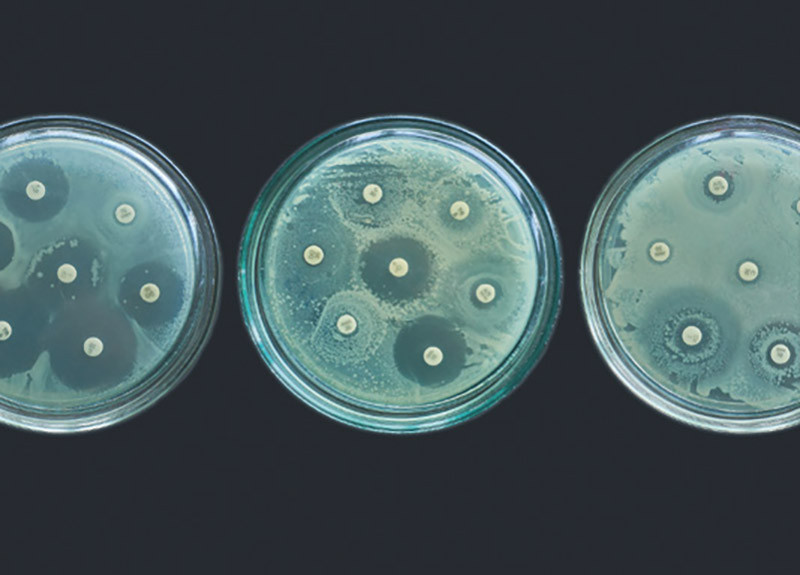

Антибиотики в животноводстве
Как снизить использование противомикробных препаратов в отрасли
Микробная антибиотикорезистентность постепенно становится глобальной проблемой. По оценкам экспертов, если не взять данный вопрос под контроль, к 2050 году от бактериальных инфекций в мире будут погибать до 10 млн человек, а убытки составят более $100 трлн в год. Причиной возникновения МАР является в первую очередь бесконтрольное применение антибиотиков в животноводстве. Впрочем, отказаться от их использования вовсе пока невозможно. Каким образом можно сократить объемы применения данных средств, рассказывает автор этой статьи.
За период существования антибиотиков — с момента открытия Александром Флемингом пенициллина в 1928 году — было разработано около 7 тыс. различных препаратов. Часть их вышла из применения из-за побочных эффектов или быстро развивающейся у микрофлоры устойчивости к противомикробным препаратам (УПП) или микробной антибиотикорезистентности (МАР). Сейчас применяются порядка 160 антибиотиков, около 20 из них — представители последнего поколения. Срок «жизни» подавляющего большинства таких препаратов колеблется в пределах от одного года до трех лет.
По данным журнала Science, в 2013 году в мировом животноводстве было использовано 130 тыс. т антибиотиков, в 2021-м — 160 тыс. т. При сохранении аналогичных темпов к 2030 году этот показатель может достигнуть 200 тыс. т. До 2017-го около 80 % всех антибиотиков, используемых в США, применялись в животноводстве. Другие источники указывают на то, что МАР имеет преимущественно медицинские корни. Так, по официальной статистике Европейского союза, пропорции применения антибиотиков в медицине и животноводстве в странах Европы существенно варьируются, но в среднем потребление данных препаратов в медицине лидирует.
Так или иначе, микробная антибиотикорезистентность постепенно переходит в разряд глобальных проблем, не только угрожающих здоровью и жизни людей, но и создающих серьезные препятствия на пути повышения ветеринарного благополучия и продуктивности сельскохозяйственных животных, а также безопасности получаемой от них продукции. По данным расследования Комиссии британского министерства здравоохранения за 2014–2016 годы, в мире в целом от бактериальных инфекций, вызванных резистентными патогенами, ежегодно умирало около 700 тыс. человек. Только в США и ЕС суммарно от болезней, вызванных МАР, количество таких смертей превышает 68 тыс. человек в год. И хотя смертность, обусловленная этим фактором, не столь велика, как, например, смертность от рака (примерно 8 млн летальных исходов в год), ожидается, что при бездействии к 2050-му бактериальные инфекции будут уносить до 10 млн жизней, а убытки превысят $100 трлн в год.
Ситуация с микробной антибиотикорезистентностью осложняется на фоне вирусных пандемий. Так, из 284,5 тыс. жизней, потерянных во время эпидемии свиного гриппа H1N1 в 2009 году, от 29 до 55 % летальных исходов были следствием вторичной бактериальной пневмонии. Вирусы, безусловно, ослабляют организм, однако причиной смерти пациентов с вирусными заболеваниями чаще всего являются трудно поддающиеся лечению присоединившиеся внутрибольничные бактериальные инфекции.
Микробная антибиотикорезистентность может становиться ключевым фактором смертности и от COVID-19, так как даже обычные коронавирусы лидируют в этиологической структуре нозокомиальных (внутрибольничных) инфекций. Например, Италия еще до вспышки в ней коронавируса была страной с самым высоким в Европе числом смертей, обусловленных МАР. Ежегодно от нее умирают около 11 тыс. итальянцев, в то время как показатель в целом по ЕС — 33 тыс. человек. Рост частоты встречаемости МАР вызван главным образом неправильным применением антибиотиков при лечении и профилактике заболеваний у людей и животных, а также перекрестным распространением между ними устойчивых штаммов микроорганизмов. Очень важную роль в распространении МАР также играет плазмидный путь (R-плазмиды) передачи генов резистентности между бактериями как одного, так и разных видов.
Заражение людей резистентными микроорганизмами приводит к серьезным заболеваниям и длительной госпитализации, к увеличению расходов на здравоохранение, к повышению затрат на лекарства и сбоям в лечении. Так, по оценке журнала Science, МАР обходится ЕС в €9 млрд в год. В США только прямые расходы на здравоохранение оцениваются в $20 млрд ежегодно, а еще $35 млрд составляют затраты вследствие потери населением трудоспособности.
С каждым годом все больше
Динамика использования антибиотиков в мировом животноводстве

Как формируется МАР
Причина возникновения микробной антибиотикорезистентности, лежащая на стыке медицинской и ветеринарной науки, — бесконтрольное применение антибиотиков в животноводстве и передача устойчивых микроорганизмов человеку при непосредственном его контакте с животными-носителями и/или через продукты питания. К этой категории микроорганизмов относятся возбудители пищевых токсикоинфекций (сальмонеллы, кампилобактерии и листерии) и зооантропонозов (болезней, общих для человека и животных), вызванных поли- либо панрезистентными энтерококками, синегнойной палочкой, кишечными палочками различных типов и пр.
Конечно, интенсивное ведение промышленного животноводства всех видов и направлений продуктивности практически невозможно без применения антимикробных препаратов. В частности, современное птицеводство — отрасль животноводства с самым высоким уровнем генетического прогресса за последние 50 лет и с самым высоким выходом готовой продукции на единицу площади или объема помещения в год. Использование противомикробных препаратов в животноводстве преследует несколько целей. Это и стимуляция роста путем сокращения сроков откорма и затрат кормов для достижения целевых показателей выращивания, и терапия для лечения больных животных или птицы. Также антибиотики применяются для профилактики при высоком риске вспышки заболевания и метафилактики, когда противомикробные препараты назначаются клинически здоровым животным, находящимся в одном стаде с клиническими больными.
В птицеводстве причины применения антибиотиков тесно связаны с физиологией птиц современных кроссов, целенаправленно выведенных с уклоном на высочайшую продуктивность в ущерб устойчивости к стрессам, с высокой концентрацией поголовья на единице площади, а также с многочисленными нарушениями и без того сложной технологии содержания. Все эти негативные факторы приводят к снижению естественной резистентности птицы, хронической иммуносупрессии и закономерному возникновению вторичных (факторных) бактериальных инфекций, требующих неизбежного применения антибиотикотерапии и интенсивных схем вакцинопрофилактики.